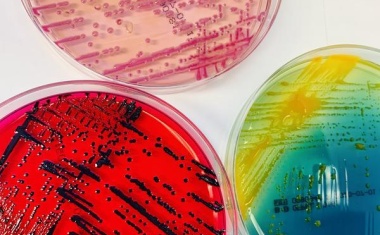
Photo

Wie sich Bakterien feindlichen Angriffen widersetzen
Wissenschaftler der Universität Basel haben festgestellt, dass bestimmte Bakterien ihre Konkurrenten mit einem molekularen Harpunensystem angreifen. Bakterienstämme, die Schutzmechanismen gegen diese Angriffe entwickeln, zeigen dabei eine erhöhte Empfindlichkeit gegenüber Antibiotika.